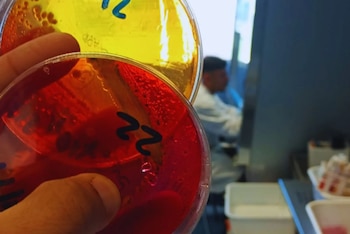
La incorporación del laboratorio garantiza la elaboración de análisis oficiales y mejora respuestas al sector productivo nacional

La Unidad de Investigación Avícola (UIA) del Instituto Nacional de Tecnología Agropecuaria Concepción del Uruguay acaba de dar un paso significativo: su incorporación a la Red Nacional de Laboratorios del Servicio Nacional de Sanidad y Calidad Agroalimentaria (RedLab).
Se trata de un reconocimiento que no solo valida el trabajo realizado, sino que también amplía el alcance y la confiabilidad de sus análisis.
En esta primera etapa, el laboratorio quedó habilitado para la detección de Salmonella spp., un avance concreto que sintetiza un proceso más amplio de mejora y consolidación, y que proyecta nuevas posibilidades dentro del sistema sanitario.

Un camino de trabajo sostenido
Llegar a la RedLab implicó cumplir con exigentes estándares vinculados a sistemas de calidad, buenas prácticas de laboratorio y competencias técnicas del equipo, en línea con normativas nacionales e internacionales. Detrás de este logro hay más de un año y medio de trabajo enfocado en ajustar procesos y fortalecer capacidades.
“El ingreso a la RedLab es el resultado de un trabajo sostenido de más de un año y medio, en el que se adecuaron procesos, se fortalecieron capacidades y se consolidó un sistema de calidad robusto”, explicó Santiago Araujo, especialista en Bromatología del INTA Concepción del Uruguay y quien lideró el proceso.
Respuestas más ágiles y confiables
Formar parte de la red asegura estándares de calidad homogéneos en todo el país y mejora el control de enfermedades, al tiempo que agiliza la gestión de muestras. En la práctica, esto se traduce en respuestas más rápidas y confiables para el sector productivo y sanitario.
En ese sentido, Araujo remarcó que “este reconocimiento no solo valida técnicamente los resultados que se generan, sino que también posiciona al laboratorio como un actor estratégico para acompañar al sector avícola con información confiable y con respaldo oficial”.
Por su parte, Francisco Federico, responsable de la UIA y director técnico del laboratorio, destacó la importancia de contar con la habilitación para Salmonella spp., ya que permite brindar respuestas analíticas rápidas con reconocimiento del Senasa, especialmente en una región donde la producción avícola tiene un rol relevante.
Un avance que abre nuevas etapas
El equipo ya trabaja en la validación de nuevos rubros, con el objetivo de ampliar la oferta de servicios y seguir acompañando las demandas del sector con estándares de calidad cada vez más altos.
La Red Nacional de Laboratorios del Senasa, integrada por instituciones públicas y privadas autorizadas para emitir resultados con validez oficial, ocupa un lugar central en el sistema sanitario argentino.
En este marco, la incorporación del laboratorio del INTA Concepción del Uruguay refuerza su compromiso con la excelencia técnica y consolida su papel dentro del entramado sanitario-productivo del país.
Fuente: Inta
Últimas Noticias
La soja, impulsada por la suba de fertilizantes, del petróleo y de los biocombustibles, reconfigura la siembra global
La crisis en Medio Oriente ¿redefine la siembra mundial y el negocio de los granos?

El agro impulsa la actividad económica
En febrero el Índice Compuesto Coincidente de la Actividad Económica -elaborado por las Bolsas de Comercio de Rosario y Santa Fe- registró su tercera suba, pero persisten señales de fragilidad en sectores como las ventas minoristas y el empleo registrado.

El Estado se queda con $62,50 de cada $100 generados por una hectárea agrícola
La suba de costos, impulsada por el aumento de la urea y los combustibles, eleva el peso de los impuestos. ¿Cómo afectan a la próxima campaña de trigo la guerra en Medio Oriente y el estrecho de Ormuz?

Un queso con identidad: Tafí del Valle logra el primer sello de origen lácteo del país
¿Puede un reconocimiento territorial transformar la proyección internacional de un alimento?

Hantavirus: crece la preocupación y se refuerza la investigación científica
El aumento de casos y la alta letalidad vuelven a poner en foco al hantavirus, mientras nuevas líneas de investigación buscan mejorar diagnóstico y tratamiento




